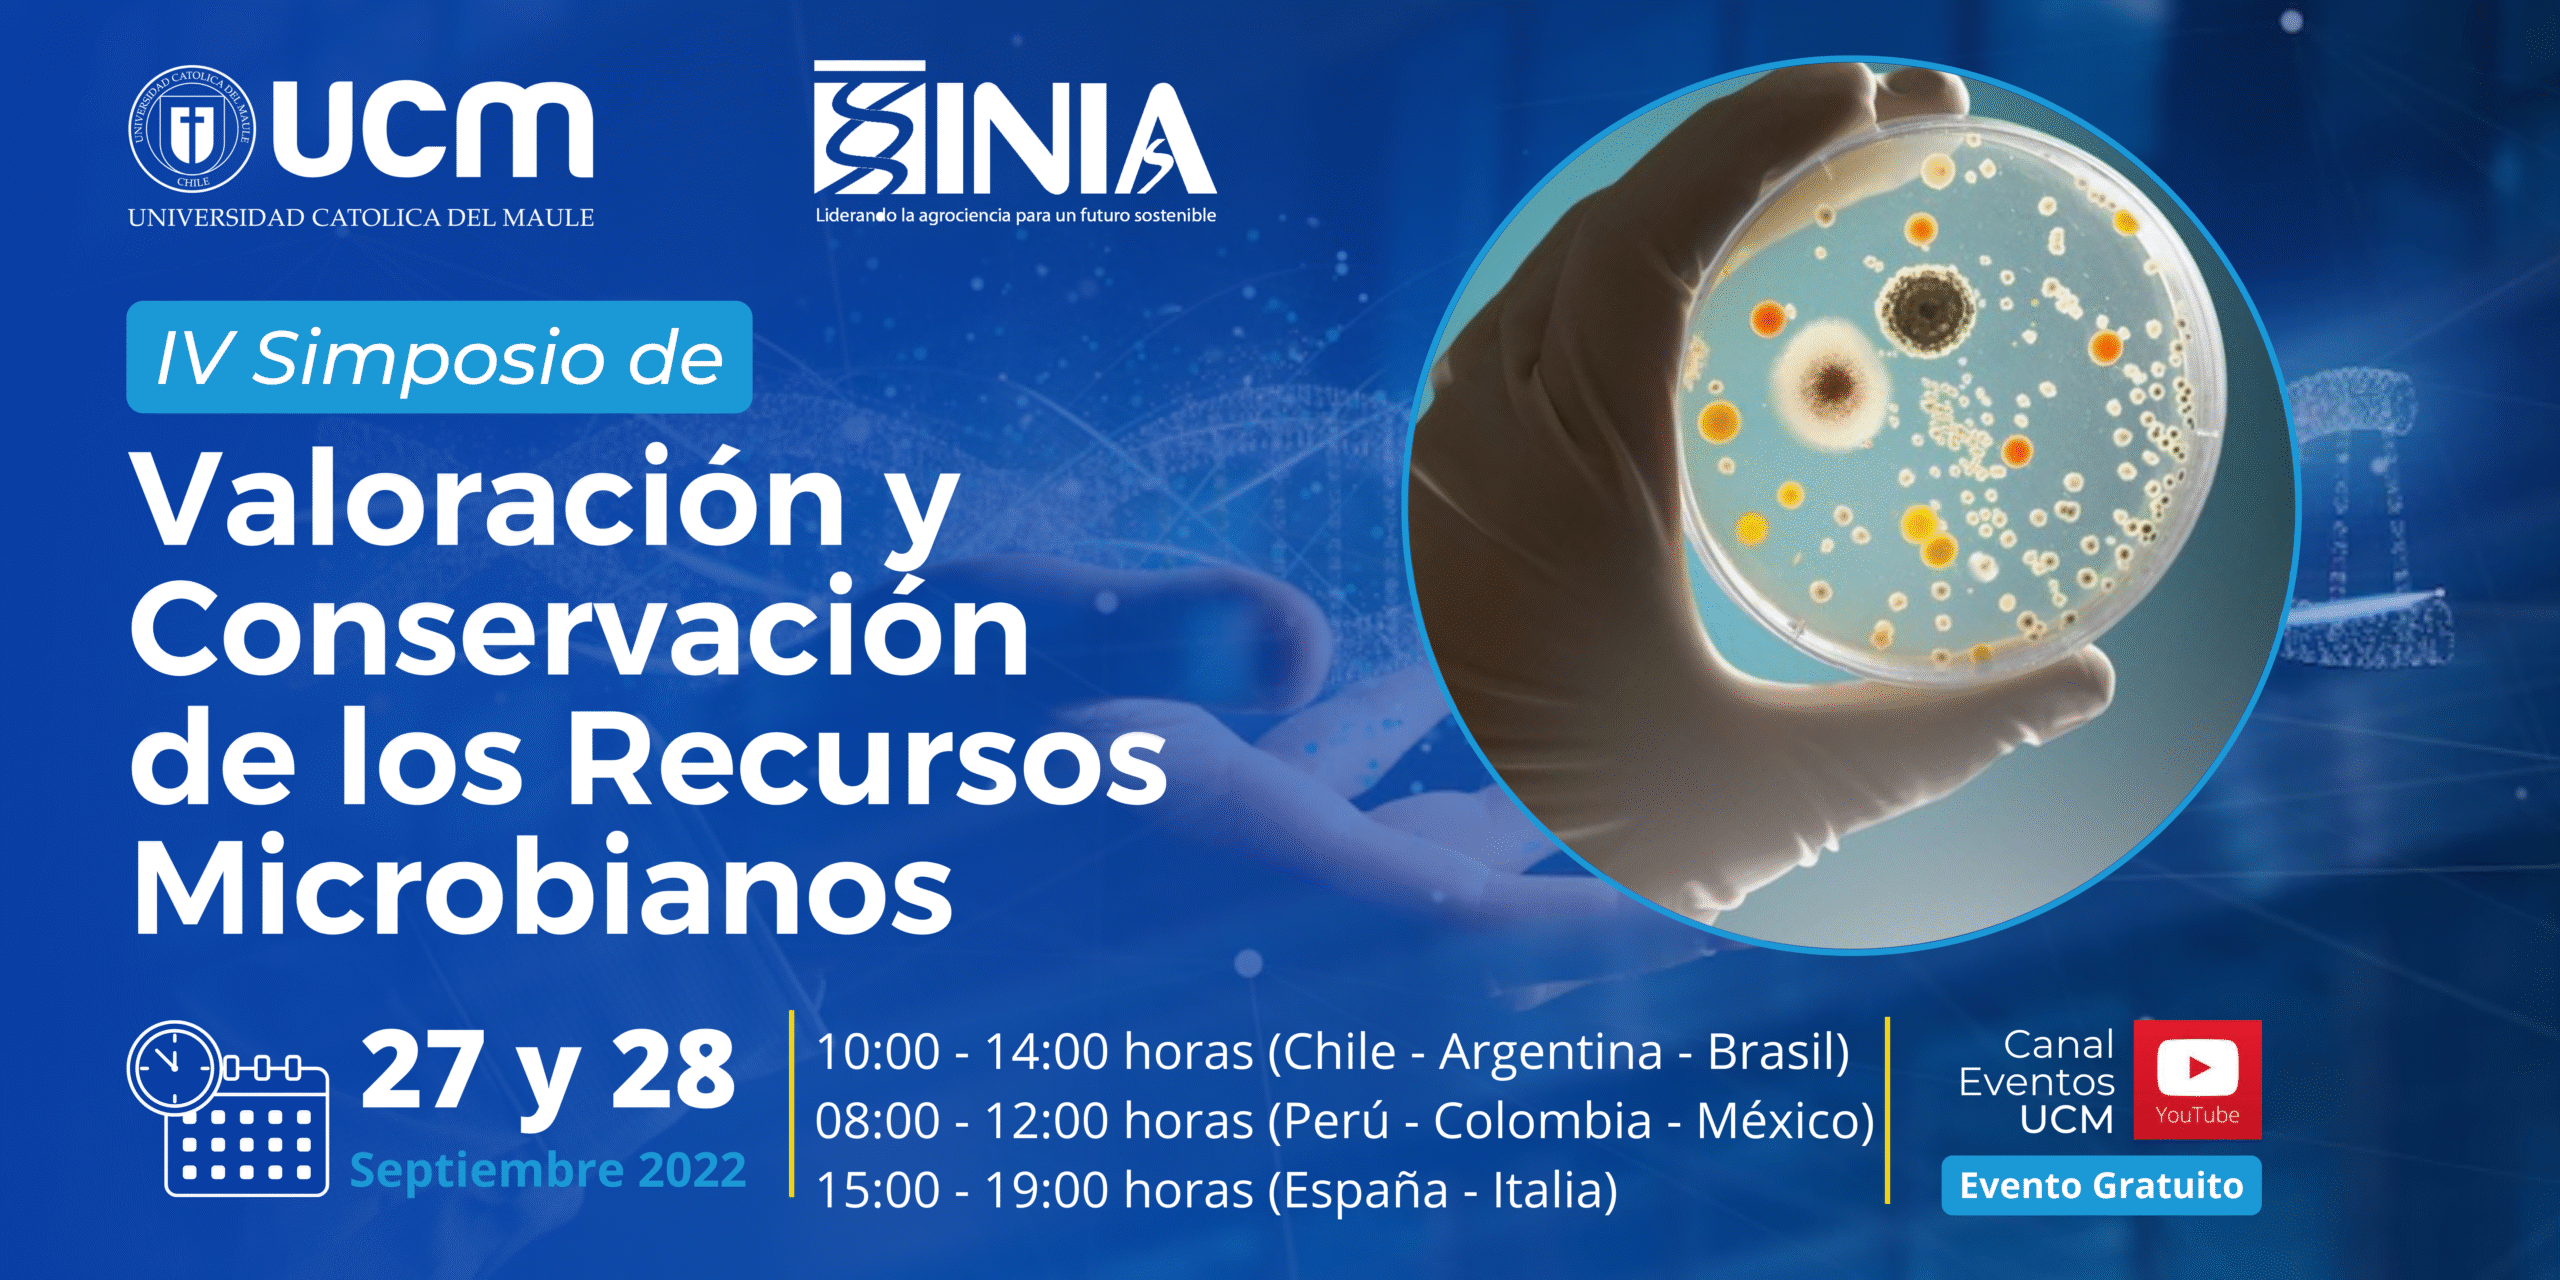
IV_SVCRM_BANNER

Los recursos genéticos microbianos son esenciales para desarrollar soluciones biotecnológicas que nos ayuden a enfrentar algunos de los grandes desafíos que tenemos como humanidad: emergencia climática, incremento en la demanda de alimentos, energías renovables, bioremediación de ambientes, entre otros.
El Instituto de Investigaciones Agropecuarias (INIA), a través del Banco de Recursos Genéticos Microbianos (BRGM), en conjunto con la Universidad Católica del Maule, tienen el agrado de invitarlos a la Cuarta versión del Simposio de Valoración y Conservación de los Recursos Microbianos a realizarse en línea los días 27 y 28 de septiembre de 2022 (10:00 AM-14:00 PM hora de Chile continental) mediante transmisión en vivo por el canal de YouTube de la UCM (revisa el horario del evento en tú país aquí).
Esta edición del Simposio tendrá un enfoque en trabajos de estudiantes e investigadores en el ámbito de metagenómica y biotecnología traslacional, pero igualmente recibimos trabajos en todos los ámbitos de la biotecnología, por lo que no dudes en enviarnos tu trabajo para revisión.
Envíanos un resumen de tu trabajo científico para ser considerado dentro de las ponencias del evento; el formato de resumen está disponible aquí. El plazo para el envío de resúmenes es hasta el lunes 01 de agosto al correo jean.castro@inia.cl. Para registrarte en el evento, completa el siguiente formulario de inscripción para participar como asistente.
El programa del evento lo podrás descargar próximamente.